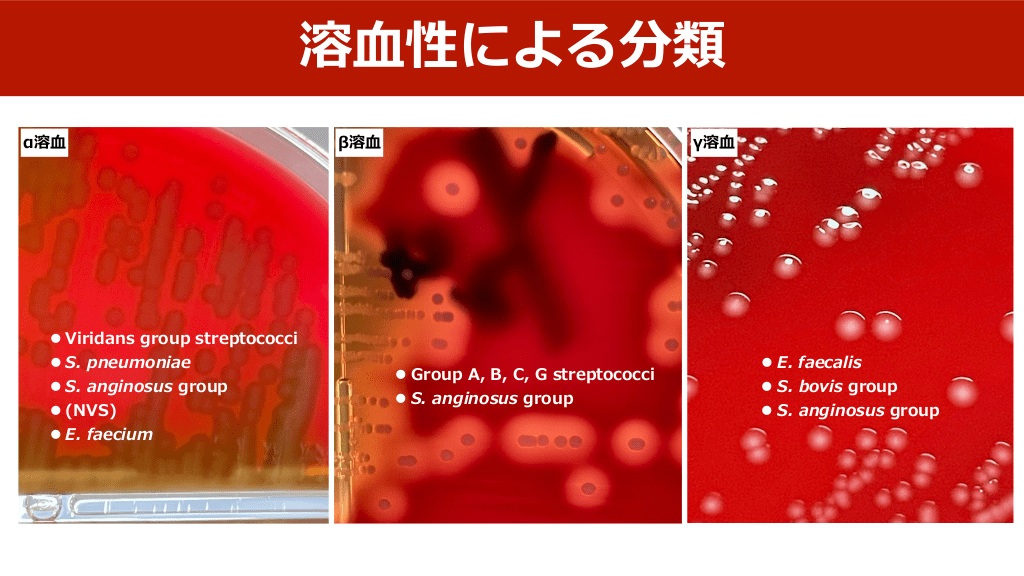
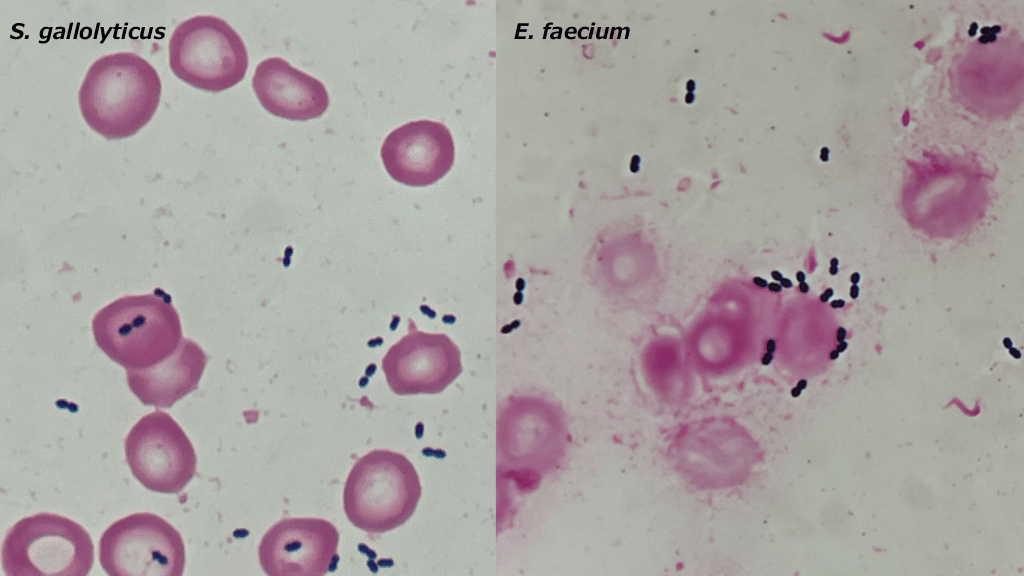
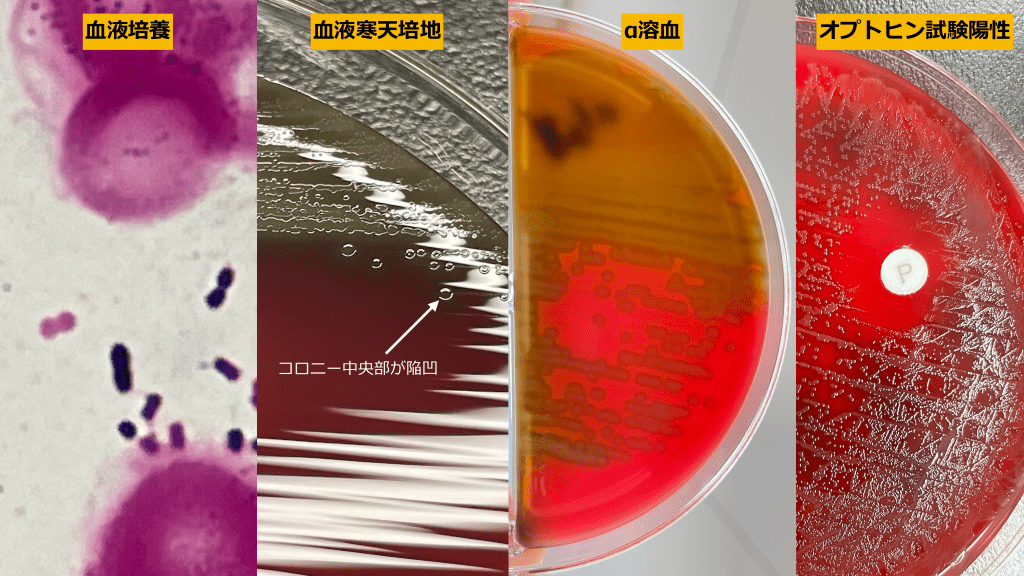
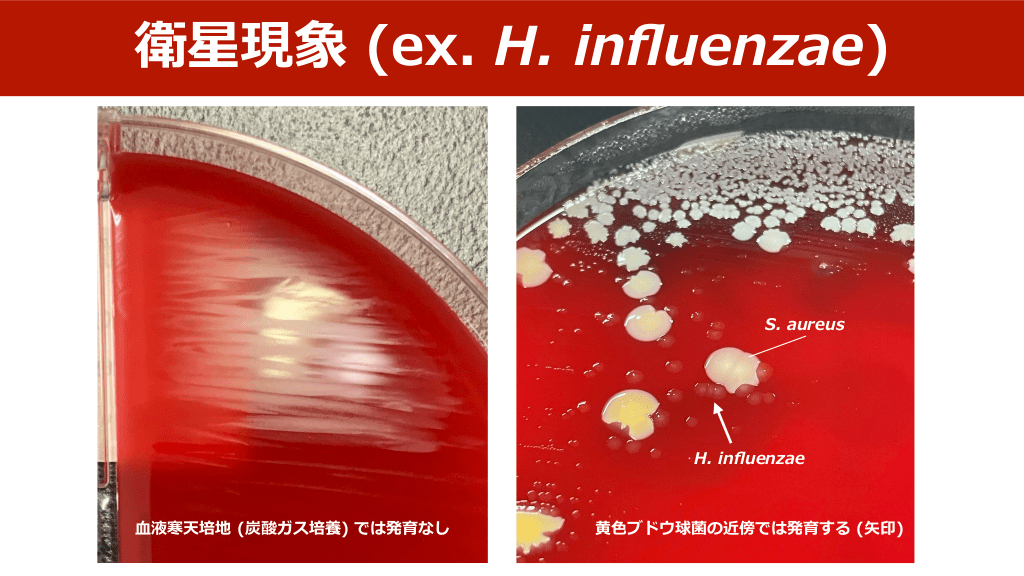

1/85
関連するスライド
劇症型溶血性レンサ球菌感染症について
長谷川耕平
78997
137
腸球菌感染症とその周辺
長谷川耕平
52983
87
感染性心内膜炎のまとめ
長谷川耕平
625762
714
小児科頻用薬について〜救急外来はこれで十分?〜救急担当 研修医必見!
どっと@小児科
168792
1409
連鎖球菌よもやま
253,372
320
概要
連鎖球菌について、ローテーター向けに作成した院内勉強会資料です。
・総論
連鎖球菌の分類
形態から推測する菌種、感染巣
菌血症の管理
・各論
Group A/B/G streptococci
Enterococcus spp.
Streptococcus bovis group
Streptococcus pneumoniae
Viridans group streptococci
Streptococcus anginosus group
Nutritionally variant streptococci
上記について、簡単にまとめました。
お時間があればぜひ。
本スライドの対象者
研修医/専攻医/専門医
投稿された先生へ質問や勉強になったポイントをコメントしてみましょう!
0 件のコメント
長谷川耕平さんの他の投稿スライド
細菌性髄膜炎のマネジメント
長谷川耕平
102,847
204
Mpox (サル痘) のまとめ (2023.04.19更新)
長谷川耕平
21,904
68
皮膚軟部組織感染症 overview
長谷川耕平
315,900
616
このスライドと同じ診療科のスライド
テキスト全文
連鎖球菌の基本情報と分類
#1.
2023.03.01 連鎖球菌よもやま 堺市⽴総合医療センター 感染症内科 ⻑⾕川耕平
#2.
今回のポイント • GPC chainは溶⾎性 (ボトル, 背景⾚⾎球)と⻑さ, 粒のサイズである程度 分類でき, 感染巣と組み合わせることである程度菌種推定は可能である • ⾎培フォローは全例必須ではないが, 菌種によってはIEリスクが⾼く, 個 別に判断する必要がある • 治療はペニシリンで概ね問題ないことが多いが, E. faeciumや肺炎球菌髄 膜炎, ⼀部のVGSでは注意が必要
GPC菌血症の重要ポイント
#3.
⽬次 • GPC菌⾎症の⾒るべきところ • GPC chainの分類と特徴 • 各論
#4.
⽬次 • GPC菌⾎症の⾒るべきところ • GPC chainの分類と特徴 • 各論
GPC chainの形態と確認方法
#5.
⾎液培養からグラム陽性球菌が⽣えた • まずは形態を確認する - GPC cluster:Staphylococcus spp., Aerococcus spp. etc - GPC chain:Streptococcus spp., Enterococcus spp. etc
#6.
GPC chainが⽣えたとき • • グラム染⾊の形態と背景を確認する - 菌⾃体のサイズ感や形:粒の⼤きさ, 正円か楕円か, 莢膜はあるか - 連鎖の⻑さ:⻑いか短いか (2-4連鎖くらいなら短い) - グラム染⾊の均質性 (グラム陽性と陰性が混在していないか) - ⾎培ボトルや背景⾚⾎球の溶⾎ 感染フォーカスがどこかを確認する
主要なグラム陽性連鎖球菌の種類
#7.
S. dysgalactiae S. anginosus E. faecium S. pneumoniae
#8.
陽性報告時 S. dysgalactiae BACTEC® 2時間後 4時間後
#9.
⽬次 • GPC菌⾎症の⾒るべきところ • GPC chainの分類と特徴 • 各論
#10.
主要なグラム陽性連鎖球菌 • Viridans group streptococci - S. mitis/oralis group - S. mutans group - S. salivarius group - S. sanguinis group - S. anginosus group - Nutritionally Variant Streptococci • Streptococcus pneumoniae • Group A, B, C, G streptococci • Streptococcus bovis group • Enterococcus spp.
感染巣と形態による推定微生物
#11.
形態と感染巣による類推 形態 感染巣 推定される微⽣物 ⻑い連鎖, 背景溶⾎+ ⽪膚軟部組織感染症 Group A, B, C, G streptococci ⻑い連鎖, 背景溶⾎+ ⾼齢者のoccult bacteremia Group A, B, C, G streptococci ⻑く⼩さな連鎖 短い連鎖, 莢膜なし 胆道系感染, 腹腔膿瘍 S. anginosus group Enterococcus spp. 短い連鎖, 莢膜あり, 多染性 肺炎, 髄膜炎, occult bacteremia S. pneumoniae ⻑く⼩さな連鎖 頸部膿瘍, 膿胸, 腹腔膿瘍 S. anginosus group 感染性⼼内膜炎疑い Viridans group streptococci Enterococcus spp. S. bovis spp. group Nutritionally Variant Streptococci Group B, G streptococci ⻑く⼩さな連鎖 短い連鎖, 莢膜なし 短い連鎖, 莢膜なし 短く⼩さな連鎖, 多染性 ⻑い連鎖, 背景溶⾎+
#12.
溶⾎性による分類 α溶⾎ • Viridans group streptococci • S. pneumoniae • S. anginosus group • (NVS) • E. faecium β溶⾎ γ溶⾎ • Group A, B, C, G streptococci • S. anginosus group • E. faecalis • S. bovis group • S. anginosus group
連鎖球菌菌血症の血培フォロー
#13.
連鎖球菌菌⾎症に対する⾎培フォロー • ⼤まかに致死的な感染症か, ⾎管内感染症を疑っているかによる • 菌種によってIEリスクは異なるため1), 個々に判断する必要がある • 明らかなfocusがあり, (可能なら)ドレナージができており, 速やかに解熱 していれば必ずしも菌⾎症全例で陰性化確認は⾏わなくてもよいが, ⾎管 内デバイス (⼈⼯弁や⼈⼯⾎管, CIEDなど), ⼼臓弁膜症, その他播種感染 の疑いがあればお勧めしている 1. Circulation. 2020;142(8):720-730.
#14.
• • IEの頻度は, VGS>>β溶連菌>肺 炎球菌 VGSと⼀括りにしても, その中で も違いはある Circulation. 2020;142(8):720-730.
治療法とペニシリンの感受性
#15.
BMC Infect Dis. 2021;21(1):689. BMC Infect Dis. 2021;21(1):689.
#16.
1セットだけ陽性になった場合 • 明らかな感染巣がない場合, Enterococcus spp.やVGSはそれぞれ70%, 30-40%がコンタミネーションの可能性がある1-2) • S. pneumoniaeやβ溶連菌は, 原則全例真の菌⾎症として扱う3) • Nutritionally Variant Streptococciについては, コンタミネーションを起 こしうるが割合は不明4) • 治療されていないなら, 全ての場合で⾎液培養の再検を⾏う 1. J Clin Microbiol. 2003;41(6):2275-2278. 2. Clin Microbiol Rev. 2006;19(4):788-802. 3. Am J Med. 2010;123(9):819-828. 4. Clin Microbiol Infect. 2018;24(9):964-969.
#17.
治療はだいたいペニシリンでok • Viridans group streptococci → MICに差はあるがほぼペニシリン感受性 • Streptococcus pneumoniae → ⾮髄液検体ならほぼペニシリン感受性 • Group A, B, C, G streptococci → 全例ペニシリン感受性として良い • Streptococcus bovis group → 全例ペニシリン感受性として良い • Enterococcus spp. → 菌種によって異なる
#18.
⽬次 • GPC菌⾎症の⾒るべきところ • GPC chainの分類と特徴 • 各論
各論:グループA, B, C, G連鎖球菌
#19.
各論 • Group A, B, C, G streptococci • Enterococcus spp. • S. bovis group • S. pneumoniae • Viridans group streptococci - S. anginosus group Nutritionally Variant Streptococci
#20.
Group A, B, C, G streptococci • いわゆる”β溶連菌(β溶⾎性連鎖球菌)“ • Group A, Group C/G, Group Bでは臨床像が異なる Lance eld PYR CAMP ⾺尿酸加⽔分解 バシトラシン感受性 S. pyogenes A ➕ ➖ ➖ ➕ S. agalactiae B ➖ ➕ ➕ ➖ S. dysgalactiae subsp. equisimilis C, G ➖ ➖ ➖ ➖ fi PYR, pyrrolidonyl arylamidase 臨床微⽣物検査ハンドブック第5版より作成
Lancefield分類と感染リスク
#21.
Lance eld分類 •逆受⾝ラテックス凝集反応 A B C を測定原理とする •被検菌と試薬を反応させる •陽性ならば凝集する fi D F G
#22.
それぞれの特徴 常在部位 S. pyogenes1-2) S. agalactiae3-4) S. dysgalactiae subsp. equisimilis5-6) 感染巣 侵襲性性感染リスク 咽頭炎, SSTI, STSS 慢性⽪膚炎, 熱傷, IVDU, 咽頭, ⽪膚表⾯>膣, 直腸 (稀に産褥期感染, 腹膜 CKD, DM, ホームレス, 鈍的 炎, ⾻関節感染など) 外傷, ⽔痘罹患後 (⼩児)など 治療 ペニシリン NSTI, STSSなら +CLDM 下部消化管, ⽣殖器 (10-40%), 咽頭 (5-20%*) occult bacteremia, 新⽣児, 産褥, ⾼齢, 肥満, SSTI, ⾻関節感染, IEな DM, CKD, 担癌, LC, 免疫抑 ど 制など ペニシリン 中咽頭, ⽪膚, 消化管, 泌尿⽣殖器 (⼥性) 咽頭炎, SSTI, ⾻関節感 ⾼齢, DM, 担癌, 免疫抑制, 染, occult bacteremia, IVDU, 慢性⽪膚炎, LC IEなど ペニシリン *MSMは咽頭保菌リスク 1. Clin Microbiol Rev. 2014;27(2):264-301. 2. Pediatr Infect Dis J. 2015;34(4):447-449. 3. Clin Microbiol Infect. 2021;27(1):129.e1-129.e4. 4. Mandell, Douglas, and Bennett's Principles and Practice of Infectious Diseases, 201, 2505-2512.e2 5. Microbiol Spectr. 2019;7(2):10.1128/microbiolspec.GPP3-0016-2018. 6. Infect Dis Clin North Am. 2022;36(4):861-887.
#23.
侵襲性S. agalactiae感染の疫学 男性 ⼥性 年齢 (%) ≦39 (3.6) 40-64 (17.3) ≧65 (31.5) subtotal (52.3) ≦39 (5.7) 40-64 (11.0) ≧65 (31.0) subtotal (47.7) total 原発性菌⾎症 35.7% 46.0% 60.1% 53.8% 55.0% 48.4% 57.6% 55.1% 54.4% ⾻関節感染 27.1% 24.5% 13.1% 17.8% 8.1% 12.6% 13.3% 12.5% 15.3% SSTI 11.4% 8.0% 11.5% 10.3% 4.5% 12.6% 14.5% 12.8% 11.5% 中枢感染 21.4% 5.9% 2.6% 5.0% 9.9% 9.3% 3.6% 5.7% 5.3% IE 2.9% 5.9% 4.7% 5.0% 2.7% 7.0% 5.6% 5.6% 5.3% 泌尿⽣殖器感染 0% 3.2% 2.4% 2.5% 18.9% 5.6% 1.3% 4.4% 3.4% 呼吸器感染 0% 2.1% 3.1% 2.5% 0% 2.3% 3.0% 2.5% 2.5% その他 1.4% 4.4% 2.4% 3.0% 0.9% 2.3% 1.2% 1.4% 2.2% Clin Microbiol Infect. 2021;27(1):129.e1-129.e4.
#24.
CAMP試験 • S. agalactiaeのCAMP因⼦が, S. aureusのβ-hemolysinに作⽤し, 溶⾎性 が増す S. agalactiae S. agalactiae S. aureus Can J Microbiol. 1980;26(4):539-542.
CLDM併用とEagle効果の考察
#25.
⾮溶⾎性S. pyogenes • S. pyogenesは2つの溶⾎毒素を産⽣1) ① 酸素依存性で不安定なstreptolysin O (sloがcode) ② 酸素安定性のstreptolysin S (SLS, 炭酸ガス培養時の溶⾎の原因, sagA〜sagIに伸びるsagオペロンがcode) • 1.1%が⾮溶⾎性で, SLSのプロモーター領域やsagAの⽋失が原因である1) • sagC⽋損による⾮溶⾎性S. pyogenesによる重症SSTIの報告あり2) 1. J Clin Microbiol. 2010;48(2):635-638. 2. J Clin Microbiol. 2013;51(6):1962-1965.
#26.
ペニシリン耐性株はいないのか? • S. pyogenesではPCGに親和性の低いPBPが発現した場合, 発育不良, 発育速度の低下, 形 態異常などが認められる1)。また, M蛋⽩産⽣が減少したS. pyogenesは, PCG耐性となる ⼀⽅で病原性を失う2) • pbp2x変異 (T553K置換) によりβLのMICが上昇しているS. pyogenes (PCG→, ABPC↑, AMPC↑, CTX↑) が最近報告されているが3), 極めて稀かつペニシリン耐性株 の報告はない • S. dysgalactiaeは, pbp2x, 1a, 2b変異によるペニシリン⾮感性株の報告がある4) • JANISの年報ではS. agalactiaeについて, PCG, ABPC, CTX のそれぞれ5.3%, 1.3%, 1.2%が⾮感性5) 1. Clin Infect Dis. 1998;26:1341-1345. 2. Acta Pathol Microbiol Scand. 1958;42:181-188. 3. Clin Infect Dis. 2020;71:201-204. 4. J Antimicrob Chemother. 2016;71(12):3376-3380. 5. JANIS 2021年1⽉〜12⽉年報(accessed Dec 25, 2022) https://janis.mhlw.go.jp/ report/open_report/2021/3/1/ken_Open_Report_202100.pdf
#27.
iGASに対するCLDM併⽤ • 侵襲性GAS感染症 (iGAS) に対しては, ペニシリン系とCLDMの併⽤が推 奨される • CLDMはリボゾームに作⽤することで, 外毒素産⽣の抑制をはじめ, Eagle e ectによらない効果やPAEを有する • iGASに対するCLDM併⽤は院内死亡率を低下させる可能性がある (aOR 0.40, 95%CI 0.15–0.91)1) ff 1. Lancet Infect Dis. 2021;21(5):697-710.
#28.
Eagle e ect • ⾼濃度の抗菌薬に曝露された細菌が, 細胞死速度の低下により, 逆説的に ⽣存するというin vivoで確認されている現象1) • 細胞壁に効果のある薬剤 (ex. βL) が, 菌量が⼗分に増え細胞分裂をあまり ⾏なっていない細菌に投与された場合に効果が落ちる可能性がある • 背景にあるメカニズムははっきりとわかっていないが2), inoculum e ect とoverlapする部分もあれば, 区別される部分もある ff ff 1. J Exp Med. 1948;88(1):99-131. 2. Trends Microbiol. 2019;27(4):339-354.
GAS/GBS/GCS/GGSの感染症リスク
#29.
CLDMの誘導型耐性と構成型耐性 • EM ≧8μg/mlの場合にCLDM ≦0.5μg/ml (Staph), ≦0.25μg/ml (Strep) - D test陰性 → CLDM感受性 (erm遺伝⼦, M phenotype) - D test陽性 → CLDM誘導型耐性 (erm遺伝⼦+) • CLDM ≧4μg/ml (Staph), ≧1μg/ml (Strep) → CLDM構成型耐性 (erm遺伝⼦+) D-test erm遺伝⼦抑制機構 EM CLDM Antimicrob Agents Chemother. 1995;39(4):797-805.
#30.
CLDM耐性でも有効なのか? • S. pyogenesの外毒素産⽣は, CLDM耐性 (誘導型 or 構成型) でも⾼容量 CLDMで抑制できるかもしれない1) • CLDM耐性 (構成型33%) のβ溶⾎性連鎖球菌による壊死性筋膜炎は四 肢切断が増える可能性がある2) 尚, S. aureusの場合, 誘導型耐性ならばCLDMでTSST-1を抑えられるか もしれないが3), 構成型では毒素産⽣を抑制できない可能性がある4) 1. J Infect Dis. 2017;215(2):269-277. 2. Clin Infect Dis. 2021;73(11):e4592-e4598. 3. Ann Clin Microbiol Antimicrob. 2018;17(1):38. 4. Infect Immun. 2001;69(5):2996-3003.
#31.
non-GASによるNSTIにCLDM併⽤は微妙 • ⽶国の⼤規模コホート研究において, non-group A/B streptococciに対す るCLDM併⽤は院内死亡率が上昇する傾向(aOR 2.60, 0.94–7.52)1) • PSMを⽤いた後⽅視的コホート(@⽇本)では, 侵襲性GBS, SDSE感染症に 対するCLDM追加は, 院内死亡率を改善しなかった (リスク差 -0.3%)2) NSTIではひとまずCLDM併⽤開始 ↓ GPC chainが原因の場合 - S. pyogenes ⇒ 継続 - Others ⇒ 中⽌検討 1. Lancet Infect Dis. 2020;S1473-3099(20)30523-5. 2. Acute Med Surg. 2021;8(1):e634.
#32.
LZDによる毒素抑制 • LZDはリボソーム50Sへの作⽤を介し, TSST-1を始めとした外毒素産⽣を 抑える1-2) • 現在, 連鎖球菌のCLDM耐性率が上昇しており, iGASに対するLZDが注⽬ されている3) • ただしGASに対するCLDMによる外毒素抑制は感受性によらないと⾔われ ており, LZDがβL+CLDMに勝るかは今後の臨床試験次第 1. Clin Infect Dis. 2006;42(5):729-730. 2. J Infect Dis. 2013;208(1):75-82. 3. Clin Infect Dis. 2022;ciac720. PMID: 36056891
#33.
GAS/GBS/GCS/GGSによるIE • IEリスクは, S. pyogenes <3%, S. agalactiae/SDSE • 1-2) 3-10% 稀ではあるが, 死亡率は⾼い3) • PCG 4-6週間とGM 2週間の併⽤を⾏うが, GMについてはPCGの感受性 が⼤抵保たれていること, トレランスがないこと, 臨床研究に基づいた 推奨ではないことから異論の提唱あり4) 1. Mandell, Douglas, and Bennett's Principles and Practice of Infectious Diseases, 80, 1068-1108.e12 2. Circulation. 2020;142(8):720-730. 3. Microbiol Spectr. 2019;7(2):10.1128/microbiolspec.GPP3-0016-2018. 4. Clin Microbiol Infect. 2020;26(6):723-728.
#34.
GAS/GBS/GCS/GGSのまとめ • GBSは原発性菌⾎症やIEリスクが他より⾼い • GGSはGASと似ているが, 基礎疾患のある⾼齢者に起こりやすい • 基本的ペニシリン系抗菌薬に感受性あり • トキシックショック症候群や壊死性筋膜炎に対するCLDM併⽤はGASの場 合のみで良い可能性が⾼い
Enterococcus spp.の特徴と感染
#35.
各論 • Group A, B, C, G streptococci • Enterococcus spp. • S. bovis group • S. pneumoniae • Viridans group streptococci - S. anginosus group Nutritionally Variant Streptococci
#36.
Enterococcus spp. • 消化管常在菌の⼀つで, γまたはα溶⾎, Lance eld D群, PYR陽性, LAP陽性, 6.5%NaCl 存在下で発育 • E. faecalisとE. faeciumがほとんどで, 時折E. casseli avusなどが検出される • グラム染⾊上, E. faecalis→肺炎球菌に似たランセット型双球菌, E. faecium→落花⽣サインが参考となるがわからないことも多い。また, Enterococcus spp.は分裂する側の先端が尖って⾒えることがある。 • Enterococcus spp.菌⾎症は, ⾼齢者, 衰弱患者, 免疫抑制状態の患者によくみられる Mandell, Douglas, and Bennett's Principles and Practice of Infectious Diseases, 200, 2492-2504.e4 fl fi Nat Rev Microbiol. 2012;10(4):266-278. 感染症学雑誌 2019;93:306-311 永⽥邦昭著, 第3版 感染症診断に役⽴つグラム染⾊
#37.
E. faecalis E. faecium
#38.
E. faecalis E. faecium E. faecium E. faeciumはうっ すらα溶⾎する
腸球菌のペニシリン耐性機序
#39.
fl • E. casseli avusは ⻩⾊のコロニー
#40.
Enterococcus spp.菌⾎症 • E. faecalis菌⾎症はenterococcal IEの90%以上, 泌尿⽣殖器の異常 (CAUTI含) との関連がより⼀般的 - E. faecalis IEは⼤腸病変 (腺腫や癌) と関連があるかもしれない • E. faecium菌⾎症は消化管や⾎管内カテーテル, 過去の広域抗菌薬使⽤, 移植, 肝硬変症との関連がより多い • E. casseli avus (E. avescens含), E. gallinarumは胆道系感染での検出 Nat Rev Microbiol. 2012;10(4):266-278. が多い fl fl Mayo Clin Proc. 2021;96(1):132-146. Clin Microbiol Infect. 2011;17(7):1078-1083. Int J Infect Dis. 2014;26:76-82. Clin Microbiol Infect. 2014;20(2):145-151. Clin Infect Dis. 2004;38(1):53-61.
#41.
感受性 ABPC IPM VCM TEIC LZD DAP E. faecalis S S S S S S E. faecium R R S S S SDD〜R E. casseli avus E. avescens E. gallinarum S S S〜I S S S Other Enterococcus spp. S〜R S〜R S S S S fl fl ※全ての菌種でTMP-SMXとAG (低濃度) は内因性耐性 Antimicrob Agents Chemother. 1999;43(10):2542-2546.より筆者作成
#42.
腸球菌に対するNOVA・DENOVA adapted NOVA1) 項⽬ Number of positive cultures ≥ 2 (N) Unknown origin of bacteremia (O) Prior valve disease (V) Auscultation of a heart murmur (A) DENOVA2) 項⽬ Pts 5 4 2 1 ≧4点でIEに対する感度97%・特異度23% Pt Duration of symptoms ≥ 7 days 1 Embolization 1 Number of positive cultures ≥ 2 1 Origin of infection unknown 1 Valve disease 1 Auscultation of murmur 1 ≧3点でIEに対する感度100%・特異度83% 1. Clin Infect Dis. 2016;63:771 2. Infection. 2019;47(1):45-50.
VREの治療と耐性の考察
#43.
Enterococcus spp.のペニシリン系耐性機序 1. PBP5の過剰産⽣ (ペニシリン系に親和性低い) - E. faecium 2. βラクタマーゼ産⽣ (Staphylococcus spp.由来) - E. faecalis 3. PBP5の突然変異 (Ldtfm) - E. faecium 4. PBP4の過剰産⽣ (PCG-R, ABPC-S) - E. faecalis Expert Rev Anti Infect Ther. 2014;12(10):1221-1236. Microb Drug Resist. 2021;27(3):291-300.
#44.
PCG-R, ABPC-S E. faecalis • 韓国の後⽅視的研究において, 295例のE. faecalis菌⾎症のうち67例 (22.7%) がPCGR, ABPC-S (PRAS) • 結果:PRASはPSASと⽐較し30⽇死亡率が⾼い (OR 2.27) • PRASのABPC・PIPC治療群における死亡率は, PCG MIC≦4→13%, MIC=8→29%, MIC≧16→41.2% • ABPC・PIPC治療群ではPRAS vs PSASで⽣存率が異なるが, グリコペプチド治療群では 差はなかった Antimicrob Agents Chemother. 2019;63(7):e00291-19. • PRASでは, PBP2変異の有無に関わらずABPC+CTRXにシナジーを有さない可能性がある Antimicrob Agents Chemother. 2023;e0087122. DOI: 10.1128/aac.00871-22 PRAS E. faecalis菌⾎症の治療戦略については今後の報告待ち
#45.
van遺伝⼦ • バンコマイシン耐性に関連する遺伝⼦ (vanA, B, C, D, E, G, L, M, N)1) • ペプチドグリカンにおける-D-Ala4-D-Ala5の”-Ala5”が, -lactate (vanA, M, B) • ⾼度グリコペプチド耐性に関連するのはvanA, Mで, vanAはトランスポゾン内 - vanCのみが内因性で, 他は獲得耐性 や-serine (vanC, D, E, G, L, M, N) に置換される2) にあり接合伝達によってVRSAの発⽣に関連する3) vanA vanC 1. Infect Drug Resist. 2015;8:217-230. 2. ⽇本臨床微⽣物学雑誌 2014;24;10-24. 3. Curr Opin Infect Dis. 2005;18(4):300-305. VCM MIC TEIC MIC 接合伝達 菌種 64-1,000 16-512 + E. faecium, E. faecalis ー E. casseli avus E. avescens 2-32 0.5-1 fl fl E. gallinarum
#46.
DAPのbreakpoint (CLSI) MIC breakpoint (μg/ml) S E. faecium only Enterococcus spp. (other than E. faecium) SDD I R 備考 – ≦4 – ≧8 SDDのbreakpointはDAP 8-12 mg/kg q24h投与下で, E. faeciumの重症感染を 対象とする。感染症専⾨医へのコンサルト を推奨 ≦2 – 4 ≧8 “S”はDAP 6mg/kg q24hを元にしている CLSI M100-ED32:2022 Performance Standards for Antimicrobial Susceptibility Testing, 32nd Editionより抜粋 • 2020年CLSIの改訂で, E. faeciumのDAPに対する”susceptible”が削除→MIC≦4μg/ mLをSDDと設定1)。⼀⽅, EUCASTではエビデンス不⼗分としてbreakpointを設定 されていない2)。 1. Clin Infect Dis. 2020;70:1240-1246. 2. Clin Microbiol Infect. 2020;26:1039-1043.
各論:S. bovis groupの特徴
#47.
DAPのポジション • DAPのMIC 2-4μg/mLであるE. faecium株に対して, DAP 10-12mg/kgを投与すれ ばfAUC/MIC≧27.4を達成できる1) • VRE患者の予後を⾒た後⽅視的研究では, DAP 8-10mg/kgが6mg/kgよりも予後・ 微⽣物学的治療成功率が⾼かった2)⼀⽅, MIC 4mg/dLのE. faecium菌⾎症をDAPで 治療すると再燃が多く, DAP ≧8mg/kgが転機に関与しない可能性がある3) • DAP 10-12mg/kgでも, E. faecalis (MIC 4mg/L) およびE. faecium (MIC 4-8mg/ L) による感染症を治療することはPK-PDデータからは難しい可能性がある4) → E. faecium菌⾎症に対するDAPは8-12mg/kg必要, かつIEなどの侵襲性感染症に対 しては慎重に使⽤するべきである 1. 2. 3. 4. Clin Clin Clin Clin Infect Dis. 2019;68:1650-1657. Infect Dis. 2017;64:605-613. Infect Dis. 2016;62(12):1514-1520. Microbiol Infect. 2020;26(8):1039-1043.
#48.
治療のまとめ ⾮複雑性菌⾎症 感染性⼼内膜炎 E. faecalis E. faecium ABPC VCM 代替薬: ・混合感染の場合:PIPC, IPM ・アレルギーの場合:VCM, DAP, LZD 代替薬:DAP, LZD ABPC+CTRX* or ABPC+GM** VCM+GM 代替薬:VCM+GM, TEIC 代替薬:DAP+GM, LZD *eGFR<60は胆泥形成リスクであり, 腹部所⾒の変化に注意 **GM≦500μg/mlならシナジーが期待できる Clin Microbiol Infect. 2021;27(3):364-371.より作成
#49.
Enterococcus spp.菌⾎症の特徴まとめ 感染巣 Rate (%) All E. faecalis E. faecium IE risk ⼼エコー source control ⾎培フォロー 抗菌薬 治療期間 原発性 22 23 20 ⾼ 必須 ー 必須 併⽤ 2-6週間 ⾎管内デバイス 15 17 10 中 推奨 推奨 必須 単剤 2-4週間 腹腔 41 30 61 低 推奨 推奨 推奨 広域 1-4週間 推奨 カテーテル関 連なら推奨 推奨 単剤 1-2週間 推奨 膿瘍などあれ ば推奨 推奨 単剤 1-2週間 ⽣殖器・尿路 SSTI 27 5 36 5 9 6 低 低 Clin Microbiol Infect. 2021;27(3):364-371.より作成
#50.
各論 • Group A, B, C, G streptococci • Enterococcus spp. • S. bovis group • S. pneumoniae • Viridans group streptococci - S. anginosus group Nutritionally Variant Streptococci
S. gallolyticusと悪性腫瘍の関連
#51.
S. bovis group • Lance eld D群, γ (または α) 溶⾎ • PYR陰性, 6.5%NaCl存在下で発育しない (Enterococcus spp.との違い) • 個⼈的には, グラム染⾊でEnterococcus spp.と⾒分けがつかない fi Mandell, Douglas, and Bennett's Principles and Practice of Infectious Diseases, 200, 2492-2504.e4
#52.
S. gallolyticus E. faecium
#53.
Biotypeごとの特徴 • S. bovis groupはbiotypeごとに細分類される1-3) 名称 備考 Ⅰ S. gallolyticus subsp. gallolyticus 連鎖球菌IEの20%を占める 結腸悪性腫瘍と関連する1) Ⅱ/2 S. gallolyticus subsp. pasteurianus 新⽣児髄膜炎2) Ⅱ/1 S. infantarius subsp. infantarius, S infantarius subsp. coli 胆道系感染3) 1. Mandell, Douglas, and Bennett's Principles and Practice of Infectious Diseases, 200, 2492-2504.e4 2. J Clin Microbiol. 2016;54(7):1694-1699. 3. J Clin Microbiol. 2008;46(4):1570.
#54.
悪性腫瘍との関連 • S. gallolyticus subsp. gallolyticus菌⾎症患者は, 他菌による菌⾎症患者 と⽐較し⼤腸悪性腫瘍が5倍多い1) • in vitroで免疫逃避による前癌病変表⾯への定着のほか, β-catenin発現 による⼤腸癌細胞の増殖と腫瘍形成を促進する2) S. infantarius subsp. infantariusは膵・胆道系悪性腫瘍との関連が⽰唆 されている3) 1. Clin Infect Dis. 2012;55(4):491-496. 2. Mandell, Douglas, and Bennett's Principles and Practice of Infectious Diseases, 200, 2492-2504.e4 3. J Clin Microbiol. 2008;46(4):1570.
S. pneumoniaeの感染症とワクチン
#55.
S. bovis groupのまとめ • Enterococcus spp.と似ているが, PYR陰性, 6.5%NaCl存在下で発育しな い点で異なる • S. gallolyticus subsp. gallolyticus菌⾎症患者ではIEを検索, ⼤腸悪性腫 瘍が隠れている可能性があり⼤腸カメラを勧める • 新⽣児髄膜炎で連鎖球菌が検出された場合, GBS以外にS. gallolyticus subsp. pasteurianusもありえる (ただし治療はペニシリン系で変わらな い)
#56.
各論 • Group A, B, C, G streptococci • Enterococcus spp. • S. bovis group • S. pneumoniae • Viridans group streptococci - S. anginosus group Nutritionally Variant Streptococci
#57.
S. pneumoniae • α溶⾎, ランセット型双球菌, 特に⾎培でグラム陽性と陰性が混在する • オプトヒン試験陽性 (CO2培養), 胆汁酸溶解試験陽性 • ⾃⼰融解し, コロニー中央部が陥凹 (⾎清型3, 37, 8はムコイド型)1) • 無症候性の咽頭定着, 局所感染 (中⽿炎, 副⿐腔炎, 肺炎), 侵襲性感染 (菌 ⾎症, 髄膜炎, 膿胸, ⼼内膜炎, 関節炎) を引き起こす2) • 基本的には横隔膜より上で病原性を発揮するが, SBPの起因菌となったり 稀に肝胆膵系腫瘍患者の閉塞性胆管炎の原因となる3) 1. J Infect Chemother. 2021;27(2):211-217. 2. Mandell, Douglas, and Bennett's Principles and Practice of Infectious Diseases, 199, 2473-2491.e5 3. J Infect Chemother. 2016;22(6):383-386.
#58.
⾎液培養 ⾎液寒天培地 コロニー中央部が陥凹 α溶⾎ オプトヒン試験陽性
S. pneumoniaeの感受性と耐性
#59.
検出部位ごとのβL-Breakpoint MIC Breakpoints, μg/ml (Rate)1-2) PCG CTRX, CTX S I R ⾮髄液検体 ≦ 2 (96.6%) 4 (2.7%) ≧ 8 (0.7%) 髄液検体 ≦ 0.06 (40.5%) - ≧ 0.12 (59.5%) ⾮髄液検体 ≦ 1 (95.9%) 2 (2.0%) ≧ 4 (2.1%) 髄液検体 ≦ 0.5 (88.8%) 1 (5.6%) ≧ 2 (5.6%) • 髄液検体 → MEPM-I 18.2%, R 6.8%, VCMは全てS, LVFX-S 97.5%, I 2.5% • 髄液以外の検体 → MEPM-I 15.2%, R 8.9%, VCMは全てS, LVFX-I 0.7%, R 6.0% 1. CLSI M100-ED32:2022 Performance Standards for Antimicrobial Susceptibility Testing, 32nd Edition 2. JANIS 2021年1⽉〜12⽉年報(accessed Dec 25, 2022) https://janis.mhlw.go.jp/report/open_report/2021/3/1/ken_Open_Report_202100.pdf
#60.
pbp変異によるBL耐性 • pbp1a, 2x, 2bが組み 合わさって耐性化する • pbp2x変異の基質は, セフェム > ペニシリ ン・カルバペネム • pbp1a/2b変異の基質 は, ペニシリン > セ フェム・カルバペネム ⽇本化学療法学会雑誌 2006;54:96-94 Kurume Med J. 2001;48(1):1-8.
#61.
侵襲性S. pneumoniae感染症 • 特に無脾症, 脾機能低下症, 補体⽋損症などでoverwhelming sepsisを引 き起こす1) • 市中発症髄膜炎の70%近くをしめ, ⾎⾏播種の他, 副⿐腔炎・中⽿炎から の直接波及が原因となる2) • 無菌検体から検出された場合, 5類感染症としての届出が必要 1. J Cell Mol Med. 2008;12(6A):2245-2254. 2. Nat Rev Dis Primers. 2016;2:16074.
#62.
肺炎球菌ワクチン • PCV13 (13価肺炎球菌結合型ワクチン), - 莢膜多糖体抗原にキャリア蛋⽩ (⾮病原性ジフテリア蛋⽩:CRM197) を ® プレベナー13 結合させ, T細胞依存性抗原にしたもの → 免疫記憶が残る (成⼈は単回)。 粘膜免疫を刺激することで⿐腔内定着を予防する。 • PPSV23 (23価肺炎球菌莢膜ポリサッカライドワクチン), ニューモバック ® スNP - 莢膜多糖体抗原はT細胞⾮依存性抗原 → 免疫記憶が残らず, ⻑持ちし ない (5年毎) ⽇本内科学会雑誌. 2015;104:2324-2329 MMWR Morb Mortal Wkly Rep. 2022;71(4):109-117.
Viridans group streptococciの感染
#63.
PCVは間接免疫を付与する FIGURE. Invasive pneumococcal disease (IPD) incidence among adults aged ≥65 years, by pneumococcal serotype* ̶ United States, 1998–2017 •⼩児のPCV接種により 65歳以上のIPDが減少 している MMWR Morb Mortal Wkly Rep. 2019;68(46):1069-1075.
#64.
⼩児から分離された⾎清型 Serotype replacementが起 こっている Emerg Infect Dis. 2018;24(11):2010-2020.
#65.
成⼈から分離された⾎清型 Emerg Infect Dis. 2018;24(11):2010-2020.
#66.
S. pneumoniaeのまとめ • α溶⾎する連鎖球菌の中で, CO2培養下でオプトヒン感受性を⽰す • 髄液・そのほかでペニシリン・セフェムのMICが異なる • pbp変異の⼊り⽅によって感受性パターンが異なり, βラクタムの中では CTRX/CTXが安定 • 侵襲性感染を起こしやすいグループを抑え, ワクチン接種を⾏う • 無菌検体からS. pneumoniaeが検出された場合は1週間以内に届出
VGSの感染リスクとHANDOCスコア
#67.
各論 • Group A, B, C, G streptococci • Enterococcus spp. • S. bovis group • S. pneumoniae • Viridans group streptococci - S. anginosus group Nutritionally Variant Streptococci
#68.
Viridans Group Streptococci (VGS) 定着部位 Viridans streptococci* S. anginosus group NVS (Granulicatella spp., Abiotrophia sp.) 中咽頭, ⽪膚, 消化管, ⼥性の泌尿⽣殖器 中咽頭, 上気道 中咽頭, 上気道 ⾮病原性部位 典型的感染像 肺, ⾻, 仙⾻褥瘡, ⾻盤, ⽪膚, 尿路(腎臓, 膀胱, 前⽴腺) ⾍⻭, 亜急性⼼内膜炎, late PVE, 菌⾎症 (好中球減少症) ⾻, ⽪膚, 脳膿瘍, ⻭性膿瘍, 肺膿瘍, 膿胸, 肝膿瘍, ⼼筋膿瘍, 尿路(腎臓, 膀胱, 前⽴腺) 肺, ⽪膚, 消化管, 性泌尿器 腹腔膿瘍, ⾻盤内膿瘍 亜急性⼼内膜炎, 菌⾎症 (好中球減少症) *S. mitis group, S. mutans group, S. salivarius group, S. sanguinis group FNや腹腔感染など明らかなfocusがなく ⾎液培養2セット以上からVGSが検出されるならIEの可能性が⾼い Mandell, Douglas, and Bennett's Principles and Practice of Infectious Diseases, 202, 2513-2520.e2
#69.
VGSに対するHANDOC score 項⽬ Pts Heart murmur or valvular disease Aetiology 1 +1 if S. bovis, S. sanguinis, or S. mutans group +1 or if S. anginosus group -1 -1 Number of cultures 2set以上陽性 Duration of symptoms Only 1 species 症状が7⽇以上 単⼀菌の菌⾎症 Community acquired 1 ≧3点でIEに対する感度100%・特異度74% → ≦2点で感染性⼼内膜炎を除外可能1) 1 1 1 ただし, IEの有無が不明な”unknown group”が全員”IE無し”に含まれている可能性があり, 仮に”全員IE”とい うworst case scenarioなら, 3点をカットオフにした場合, 感度36%・特異度73%になると指摘されている2) → 個⼈的にはあくまで参考所⾒という位置付け 1. Clin Infect Dis. 2018;66:693 2. Clin Infect Dis. 2018;66:1819
#70.
BMC Infect Dis. 2021;21(1):689. BMC Infect Dis. 2021;21(1):689.
S. anginosus groupの感染機構
#71.
発熱性好中球減少症におけるVGS菌⾎症 • 好中球減少に加えて, 化学療法に伴う粘膜炎は原発性VGS菌⾎症の原因と なるため, FN患者の診察では⼝腔や消化器症状 (下痢) の有無を確認する1) • S. mitis/oralisが最多で, ショックやARDSなどの重篤な合併症を引き起こ すことがある2-3) • 担癌患者において, FQやTMP-SMXの使⽤は, ペニシリン耐性VGSと関連 している可能性がある4) 1. Clin Microbiol Infect. 2001;7(3):152-157. 2. Clin Infect Dis. 2000;31(5):1126-1130. 3. Clin Infect Dis. 2011;52(4):e56-e93. 4. Clin Infect Dis. 2002;34(11):1524-1529.
#72.
VGSのまとめ • IEが最も重要な感染巣で, 菌種によってリスクは異なる • HANDOCスコアで提唱されている項⽬は臨床でも重要 • 粘膜炎のあるFN患者では侵襲感染リスクあり, βラクタム耐性株が問題に なる
#73.
各論 • Group A, B, C, G streptococci • Enterococcus spp. • S. bovis group • S. pneumoniae • Viridans group streptococci - S. anginosus group Nutritionally Variant Streptococci
#74.
S. anginosus group • 中咽頭, 尿⽣殖器, 消化管の微⽣物叢の⼀種で, 頭頸 部・肺・腹腔などに嫌気性菌を含めた複数菌による膿 瘍を特徴する1) • グラム染⾊では⼩さな⻑い (時に短くグラム不定の) 連 鎖を形成 • コロニーは⼩さく, 溶⾎性は菌種によって様々 • VP反応陽性 (GAS/GCS/GGSでは陰性) 1. Front Microbiol. 2022;13:956677. β溶⾎
栄養要求性連鎖球菌の特徴
#75.
S. anginosus group S. anginosus, S. constellatus, S. intermedius - β溶⾎+Lance eld F群 → S. constellatus - α or γ溶⾎+Lance eld F群 → S. intermedius - α, β, γ溶⾎+Lance eld F群以外 → S. anginosus fi fi Mandell, Douglas, and Bennett's Principles and Practice of Infectious Diseases, 203, 2521-2525.e2 fi •
#76.
S. anginosus group • S. intermedius, S. constellatusはヒアルロニダーゼ (HAase) を分泌し, S. anginosus subsp. anginosusは⾮分泌1) - • S. intermediusの分泌するHAase (Si型) はヒアルロン酸+コンドロイ チン酸を分解できるが, S. constellatusのHAase (Scc型) はヒアルロン 酸のみ分解する2) S. intermediusのみ, シアリダーゼを分泌する1) - シアリダーゼ:宿主細胞の表⾯に存在する糖タンパク質や糖脂質のシア ル酸 (細胞表⾯の親⽔性向上+感染に対するバリアの役割) を分解する2) 1. Int J Syst Evol Microbiol. 2013;63(Pt 7):2506-2519. 2. ⽇本細菌学雑誌 2008;63:425-435
#77.
S. intermedius S. intermediusによる深部臓器感染機構の作業仮説 • インターメディリシン (ILY) と いう, ヒト⾎液寒天培地で溶⾎ を⽰す溶⾎毒素を持つ • 脳細胞・肝細胞はILY感受性が ⾼い ⽇本細菌学雑誌 2008;63:425-435
#78.
S. anginosus group • S. anginosusは⿐咽頭・頸部を始め腹腔⾻盤膿瘍, S. constellatusは胸 部, S. intermediusは肝膿瘍・脳膿瘍で検出されることが多い1-2) • 疫学的にIEは少ないが, 起こさないわけではない3-4) →S. anginosus group菌⾎症患者では膿瘍が形成されていないか検討する 1. 2. 3. 4. Front Microbiol. 2022;13:956677. Sci Rep. 2020;10(1):9032. Circulation. 2020;142(8):720-730. Clin Infect Dis. 2018;66:693
全体のまとめと今後の展望
#79.
各論 • Group A, B, C, G streptococci • Enterococcus spp. • S. bovis group • S. pneumoniae • Viridans group streptococci - S. anginosus group Nutritionally Variant Streptococci
#80.
栄養要求性連鎖球菌 NVS, Nutritionally Variant Streptococci • Abiotrophia defectiva, Granulicatella spp. (G. adiacens, G. elegans etc) • グラム陽性連鎖球菌だが, グラム染⾊不定で形態学的にも多型性をもつ1-2) • 発育にL-システイン, ビタミンB6を必要とし, ⾎液寒天培地にはほとんど発育せ ず, チョコレート寒天培地やブルセラHK寒天培地で炭酸ガス培養や嫌気培養に よって発育を認める3) • Staphylococcus spp.の産⽣するV因⼦ (NAD, nicotinamide adenine dinucleotide) をNVSが利⽤ → ⾎液寒天培地のS. aureusやS. epidermidisの 近傍でα溶⾎するコロニーを形成 (衛星現象) 1. Mandell, Douglas, and Bennett's Principles and Practice of Infectious Diseases, 202, 2513-2520.e2 2. 臨床微⽣物 2014:25;10-18 3. 医学検査 2015:64;421-427
#81.
栄養要求性連鎖球菌 NVS, Nutritionally Variant Streptococci • IEの起因菌として多いのはGranulicatella spp.>Abiotrophia spp.1) • PCG低感受性株 (MIC≧ 0.25 μg/mL) が半数以上を占めると報告されて いるが1), 感受性検査が難しく必ずしも正確ではない。 → IEの場合, PCG, CTRX, or VCM 6週間 + GM ≧ 2週間 1. J Infect. 2022;S0163-4453(22)00056-1.
#82.
Granulicatella adiacens ⾎液培養塗沫 コロニー塗沫 Korean J Clin Microbiol 2008;11(1):63-65.
#83.
衛星現象 (ex. H. in uenzae) S. aureus H. in uenzae ⻩⾊ブドウ球菌の近傍では発育する (⽮印) fl fl ⾎液寒天培地 (炭酸ガス培養) では発育なし
#84.